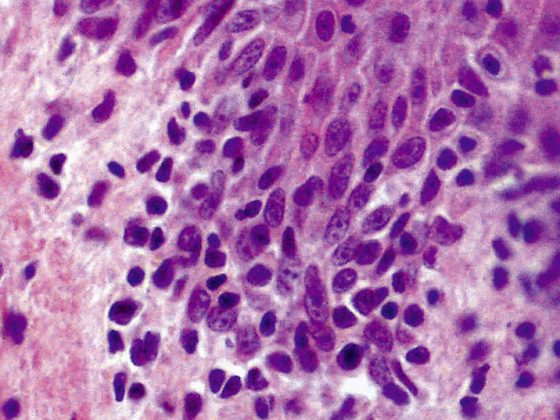
micosis_fungoides_wikimedia

Dass es eine positive Korrelation gibt zwischen Psoriasis und Depression ist bereits länger bekannt. Wie eine aktuelle epidemiologische Studie aus Dänemark zeigt, weisen auch weitere psychische Störungen bei Psoriasisbetroffenen höhere Komorbiditätsraten auf als in der Allgemeinbevölkerung.
Zurück zu «Atopische Dermatitis und Psoriasis-News»